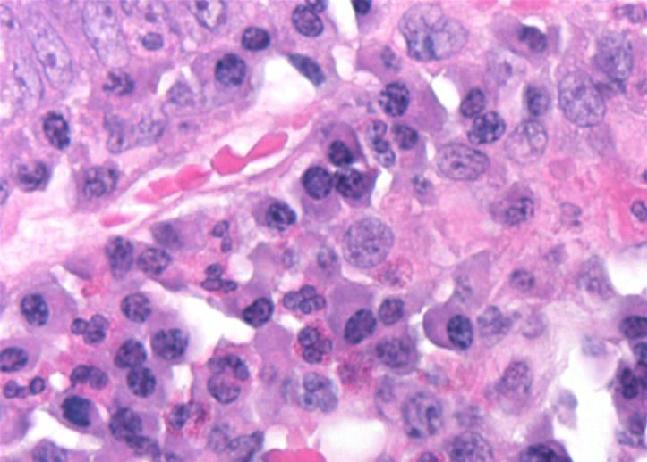

Modified hematoxylin according to Mayer. Weaker intensity reagent for progressive staining in histopathology and counterstaining in immunohistochemistry. For histology use and immonuhistochemistry use
100 ml
La documentation sera disponible sous peu. En attendant, vous pouvez nous contacter par email à l'adresse specialist@histoline.com